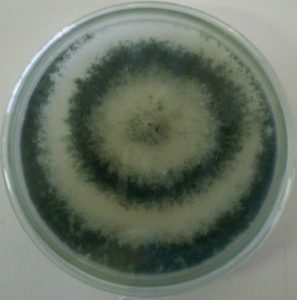

Kelebihan Pupuk Hayati Untuk Perkebunan Kelapa Sawit
Pupuk hayati kini menjadi salah satu solusi utama untuk meningkatkan produktivitas dan keberlanjutan dalam budidaya kelapa sawit. Penggunaan pupuk hayati berbasis mikroba, terutama yang mengandung
Dapatkan informasi seputar pertanian

Pupuk hayati kini menjadi salah satu solusi utama untuk meningkatkan produktivitas dan keberlanjutan dalam budidaya kelapa sawit. Penggunaan pupuk hayati berbasis mikroba, terutama yang mengandung

Penyakit Ganoderma adalah salah satu ancaman terbesar bagi perkebunan kelapa sawit di seluruh dunia. Serangan jamur ini dapat menyebabkan kerugian signifikan dan bahkan kematian tanaman,

Ketahanan tanaman kelapa sawit terhadap penyakit dan kondisi lingkungan yang ekstrem adalah kunci keberhasilan dalam budidaya kelapa sawit yang berkelanjutan. Ancaman utama seperti penyakit Ganoderma

Di tengah tantangan perubahan iklim dan meningkatnya permintaan pangan global, petani kelapa sawit perlu beradaptasi dengan praktik pertanian berkelanjutan untuk menjaga produktivitas. Salah satu solusi

Penyakit Ganoderma adalah ancaman serius bagi perkebunan kelapa sawit di Indonesia, menyebabkan kerugian besar dengan memicu kematian mendadak pada pohon sawit. Penyakit ini, yang disebabkan

Pertanian modern semakin mengarah pada praktik yang ramah lingkungan dan berkelanjutan. Salah satu inovasi yang mendukung tujuan ini adalah penggunaan pupuk hayati dan biostimulan berbahan
Trichoderma, adalah kelompok jamur tanah yang dikenal dengan berbagai manfaatnya dalam pertanian, memainkan peran penting sebagai pemacu tumbuh tanaman. Kemampuan Trichoderma untuk meningkatkan pertumbuhan tanaman

Trichoderma, adalah nama kelompok jamur yang umumnya terdapat di tanah, dan dapat berperan sebagai pengendali penyakit yang ditularkan melalui tanah, telah menarik perhatian luas dalam

Dekomposer adalah organisme pengurai, atau organisme yang berperan dalam mendekomposisi biomassa di alam. Peran organisme pengurai pada suatu ekosistem sangatlah penting. Dapat kita bayangkan apabila

Microbial Technology & Inoculant Provider
© PT Agro Hayati Persada